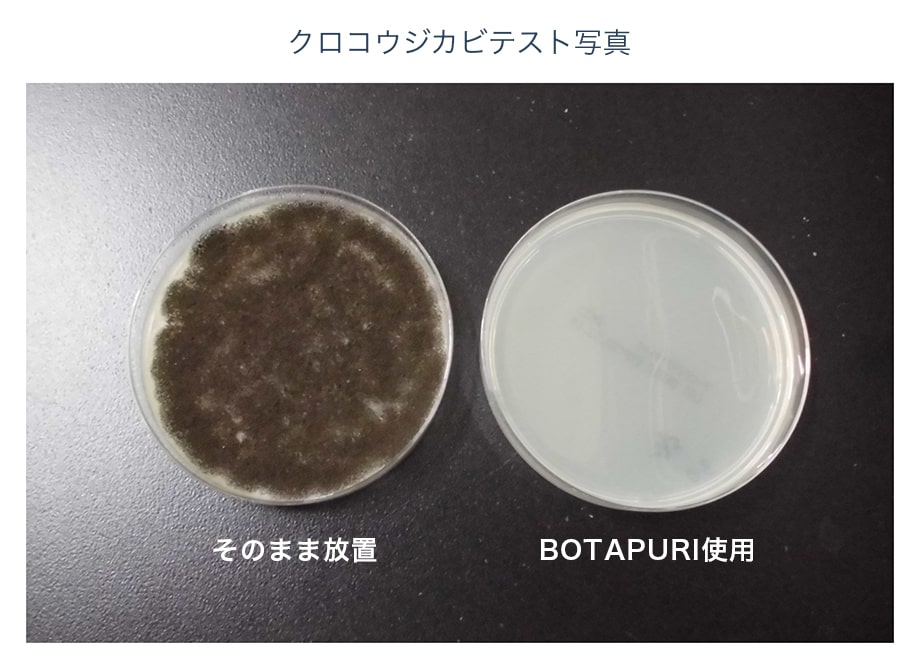
クロコウジカビテスト写真

ボタピュリ
安心安全な100%植物由来成分ながら、アルコールや次亜塩素酸に負けない驚異の除菌・消臭効果を実現しました。
インフルエンザウィルス、ネコカリシウィルス、大腸菌は10分後、クロコウジカビも30分後にはその99.9%を除菌*します。
ボタピュリとは・・ボタニカルピュリファイ 植物と浄化するから作った造語です。植物由来原料から出来た除菌消臭剤を表しています。
* 食環境衛生研究所によるテストで効果が実証されています。



空間や物だけではなく、ペットまで。安全に使用でき、用途が広い製品です。
ボタピュリ生活空間除菌消臭スプレーは100%食品素材由来成分(有機酸オリゴマー、グレープフルーツ種子抽出物)を使用し、製品は全て国内生産。
安心・安全を追求しながらも、アルコールや次亜塩素酸に負けない除菌・消臭効果を実現しました。アルコールが苦手な方や皮膚の弱い方にも自信を持っておすすめできる製品です。
ボタピュリは食品素材を発酵したものを原料としており、化学薬品や界面活性剤、防腐剤は一切使用しないため、お子様やペットが口にしても安全です。空間、物、人、ペット等、幅広い用途にお使いいただけます。
使用シーン例
お部屋、トイレ、キッチン用品、マスク、ペット関係、馬具・馬(厩舎)、冷蔵庫、おもちゃ等

専門の研究機関からも効果の高さが裏付けされています。
ボタピュリ生活空間除菌消臭スプレーは、食環境衛生研究所によるテスト結果*でも効果が実証されています。
菌・ウィルス減少率
| インフルエンザウィルスSwine Influenza Virus | 99.9%減少(10分後) |
|---|---|
| 大腸菌Escherichia Coli (Bacteria) | 99.9%減少(10分後) |
| ネコカリシウィルスFeline Calicivirus | 99.9%減少(10分後) |
| クロコウジカビAspergillus Niger (Mold) | 99.9%減少(30分後) |
* テスト結果の詳細はこちらよりご確認ください。

このような方に自信を持ってお勧めします。
- 人体に無害なものを使いたい
- アルコールで手が荒れて困っている
- 保存料や添加物が入っていないものがよい
- 赤ちゃんペットにも安心なものがよい
- 除菌、消臭効果が強力なものがよい
- 他の容器に移しても効果が落ちないものがよい
- 除菌液としても消臭スプレーとしても使えるものがよい


ボタピュリには信頼される理由があります。
- 高い安全性(100%自然由来)
- アルコール
不使用 - 添加物・保存料
不使用 - 強力な除菌力
- MADE IN
JAPAN - その場で効果
実感 - におい戻りなし
- 効果が長く続く

ボタピュリを使用されたお客様から、喜びの声が届いています。
-
トイレの臭いが想像以上によくとれ、すぐ後に別の人がトイレに入っても安心できました。(30代・女性)
-
マスクの臭い取りや除菌に最適で手放せなくなりました。今では家族全員が持ち歩いています。(30代・男性)
-
ナチュラル系素材の製品だけあって、本当に科学的な嫌な臭いが一切しませんでした。(40代・女性)
-
二酸化塩素スプレーと比較したところ遜色ない効果で驚きました。瞬間的に1番効くのは消毒用エタノールスプレーだと思いますが、私のような下戸には辛いため助かってます。(50代・男性)
-
キッチンの定期的にカビが発生するところに使用したら翌週にはカビが見当たらなくなりました。(30代・女性)
-
本当に臭いの戻りがなく驚きました。(20代・女性)
-
エアコンの掃除をした際に、仕上げとしてカビが発生しそうな熱交換器のフィンに噴霧しています。(50代・男性)
-
ペットの水ザラのヌメリ取りに使っています。犬の唾液がアルカリ性なのでちょうどいいのかも。(60代・女性)
-
長年悩んでいた猫のベッドの臭いがしなくなりました。(40代・男性)
-
乗馬クラブの厩舎で使用してます。消臭効果が高く馬にも安心なのは嬉しいですね。(60代・女性)
-
紫外線がNGの次亜塩素酸水を市販のミニ透明容器に入れて持ち歩いてましたが、少し効果が落ちてるよなあと思いながらも、持ち歩いてるのは安心感からでした。
このBOTAPURIは紫外線があっても効果が落ちないので、菌への効果が10分後とはいえ、使うタイミングをおさえておけばすごく優れものだと思います。(20代・女性)
BOTAPURI 生活空間除菌消臭スプレー
<アルコールフリー> <無香料>
100% Plant Origin Formulation Disinfectant & Deodorizer
Alcohol-Free, Fragrance-Free, Catalyst-Free
Surfactant-Free, Preservative-Free
Bacteria Removal ・ Deodorizing ・ Antifungal Effect
名称:ボタピュリ除菌消臭スプレー
成分:水、有機酸オリゴマー、グレープフルーツ種子抽出物
内容量:300ml
使用例:生活環境やペット、室内、非加熱式加湿器、マスク、水まわり、トイレ、衣類、靴、キッチン、玩具、冷蔵庫、下駄箱、喫煙所、ゴミ箱、生ゴミなど、幅広い環境でご使用いただけます。
使用方法:気になるところにスプレーを噴射するだけ
■ スプレー噴射の目安
殺菌効果試験の結果について
BOTAPURIでは、その殺菌効果について検査機関による検査を行っております。検査の詳細・結果は下記よりご確認ください。
使用上の注意
- よく振ってからご使用ください。
- 本品は、酸性なのでアルカリ性薬剤と混ぜて使用しないで下さい。
- 本品は飲用ではありません。
- 毛づくろいなど、ペットがなめても安心です。使用回数についてはペットや冷蔵庫など、大きさが違えば必要な回数は異なります。
- 高温多湿、直射日光を避け冷暗所保管して下さい。開封後は早めにお使い下さい。
製造販売元:株式会社 SK Art